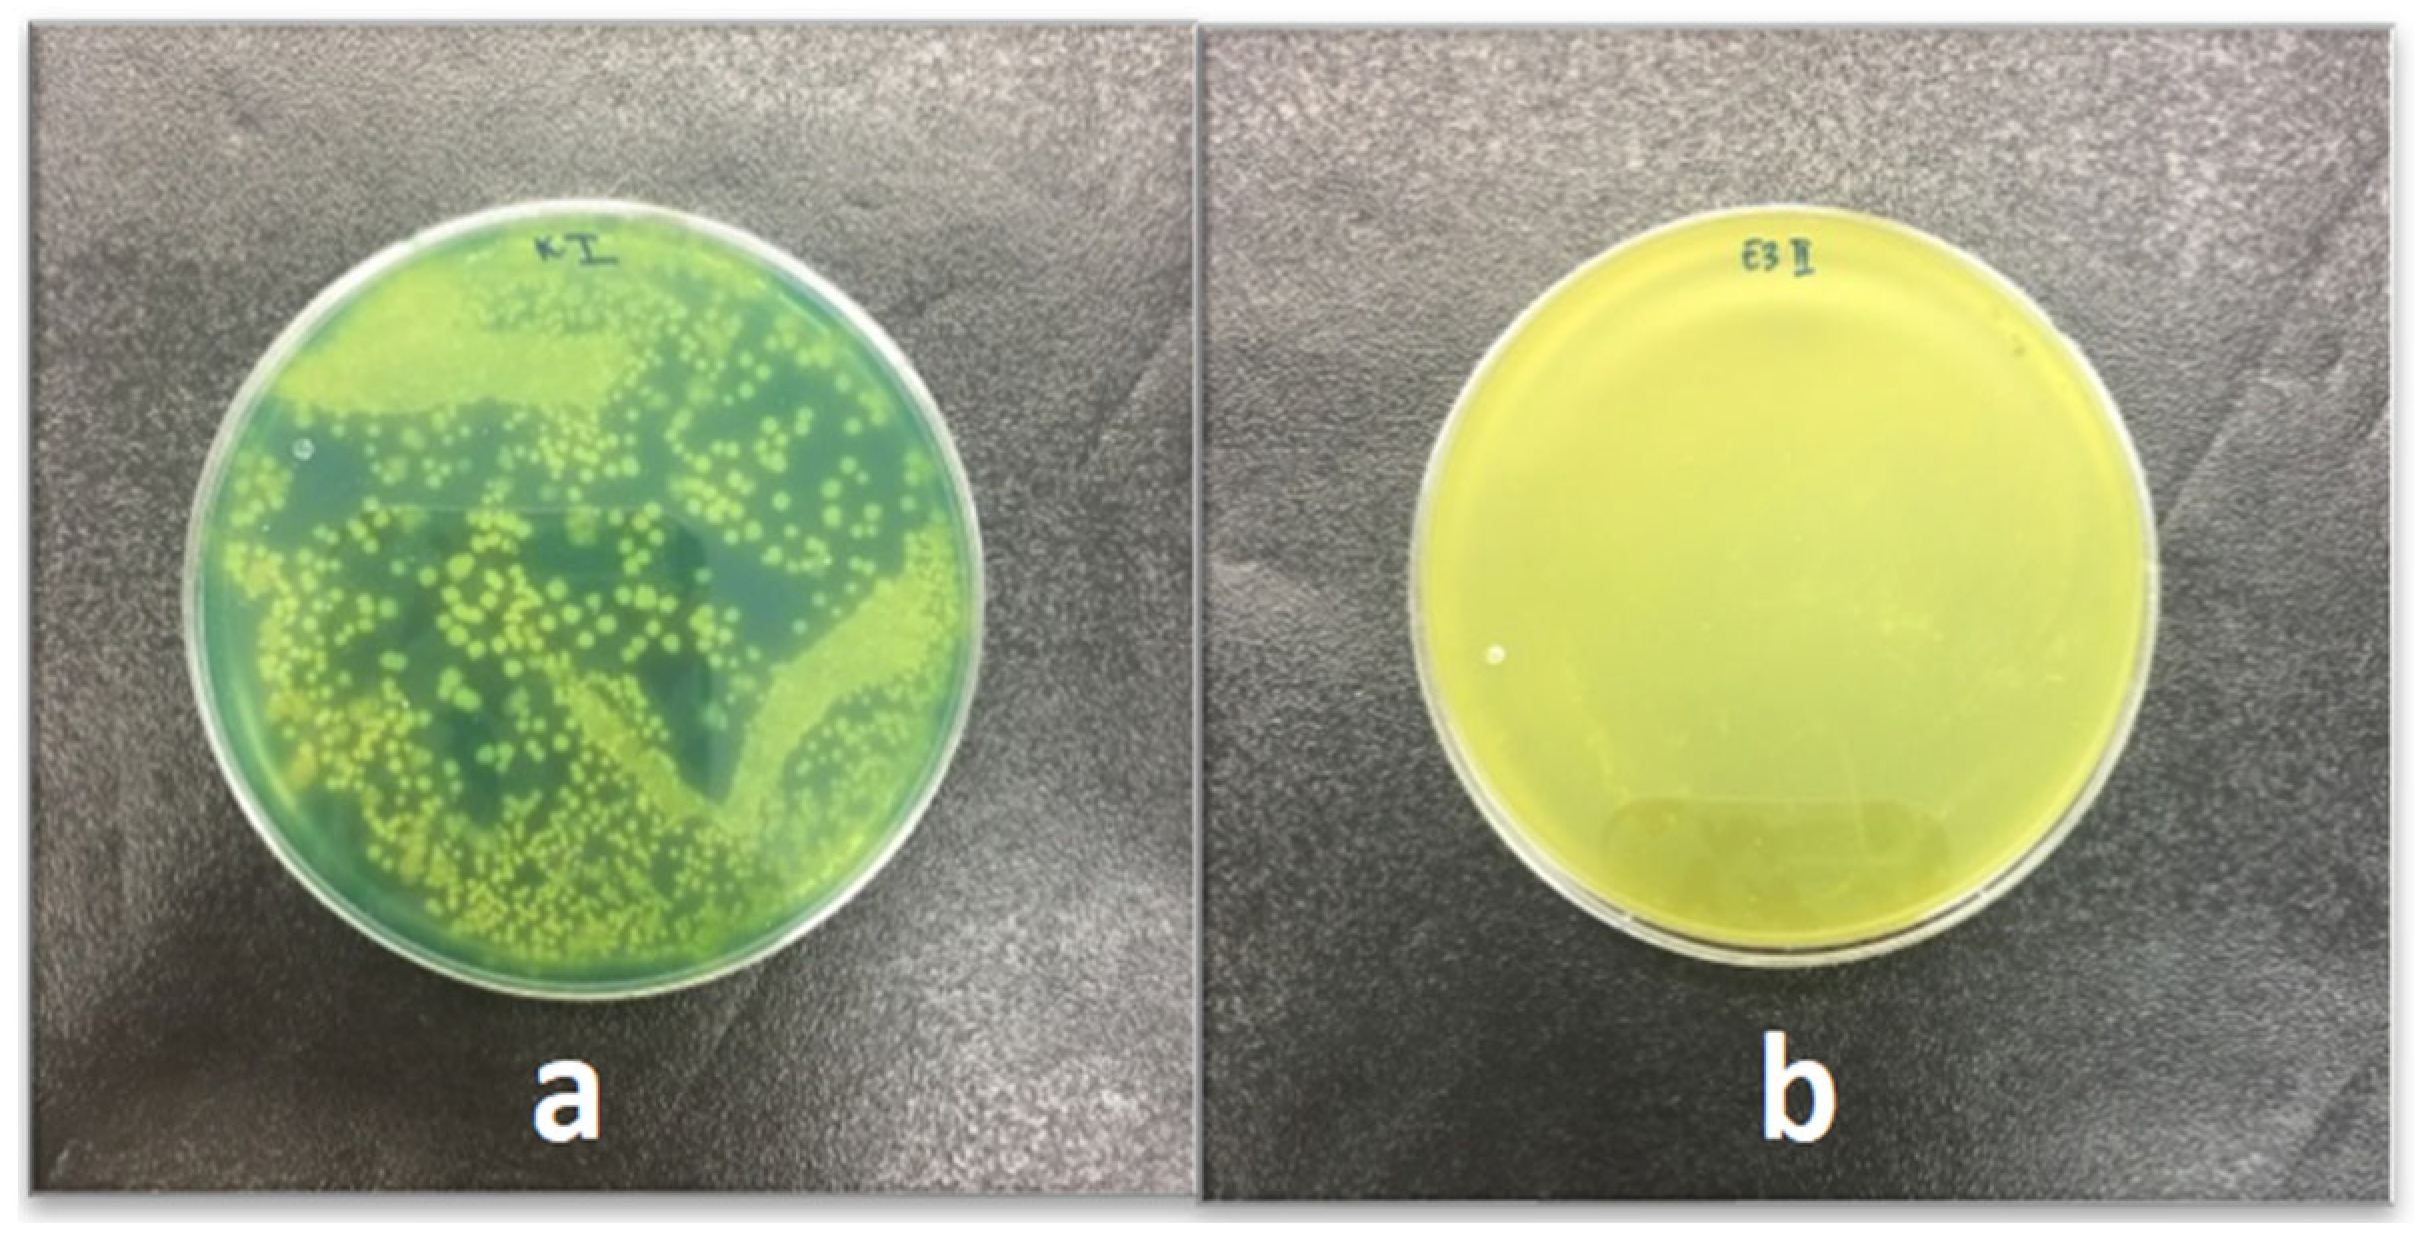
Applsci 14 03603 g001 Applsci 14 03603 g001

Abstract
To improve the nutritional value of bread, as well as to satisfy consumers whose awareness of the importance of nutrition to preserve health is growing significantly, it is desirable to enrich bread and bakery products with functional components. Carob (Ceratonia siliqua L.) is an evergreen tree that is widely distributed in the Mediterranean region and belongs to the legumes group. As carob pulp contains a unique combination of polyphenolic compounds and dietary fibre, it can be a useful raw material for the production of enriched bakery products. In this work, the possibility of applying carob extract as a potential natural preservative and functional additive in the production of bread was investigated. With this aim, 0.5, 1.5, 2.5 and 3.5% of powdered carob extract (CP) were added to bread dough and the quality characteristics of the bread were examined. The microbiological quality of bread was significantly better in samples with the addition of CP, which was confirmed by the lower values of the total number of bacteria and the absence of the Bacillus cereus. The addition of up to 3.5% carob extract had no negative effect on the sensory quality of the bread. The brightness of the bread samples decreased (L*), while the proportion of the red tone (a*) increased, and the intensity of the yellow tone (b*) decreased with an increase in the proportion of CP. The amount of total phenols (0.27 mg GAE/g) for the sample with 3.5% CP in bread was significantly higher compared to the control sample (0.12 mg GAE/g). The total antioxidant activity also increased significantly with the increase in the proportion of CP. Therefore, the present study proves that powdered carob extract can be successfully included in the production of a healthy functional food.
1. Introduction
Recently, numerous epidemiological studies have proven the potential role of foods enriched with flavonoids in reducing the risk of various diseases (cancer, coronary heart disease or neurodegenerative diseases) [1]. Due to their easy availability and high prevalence in the daily diet, bread and bakery products are an ideal matrix for the enrichment and reduction of nutrient deficits [2]. Bread enriched with antioxidants and phenolic compounds can play a role in maintaining the health of consumers [3]. Polyphenolic compounds are unstable under the influence of pH, temperature and light access, which can lead to their loss during production processes. For that reason, the use of polyphenolic compounds for the fortification of bakery products is very limited [4]. Therefore, for the enrichment of bread, powders are used that are rich in bioactive units, which are protected by microencapsulation with the use of a carrier, usually maltodextrin and inulin [5]. On the other hand, bread is a product that has a short shelf life, and in order to ensure better quality and health safety and to extend the shelf life of the product, synthetic or natural additives and antimicrobial agents are used in the breadmaking industry [6]. Synthetic additives are widely used in food production because they have high antimicrobial activity, low cost and are easily available. The safety of synthetic additives is increasingly questioned because they are considered responsible for many carcinogenic and teratogenic phenomena, as well as toxicity [7]. Therefore, increasing attention is paid to plant derivatives as an alternative to prevent the proliferation of microorganisms [8], whose use will ensure a longer shelf life of food products. Many studies have shown that some plants produce biologically active compounds that possess significant antimicrobial activity [9]. Recently, the antimicrobial effect of various plant extracts against certain pathogenic species has been observed [10]. The use of natural antimicrobial substances such as organic acids, essential oils and plant extracts can be a good way to prevent the spoilage of food and bakery products [11].
During the last two decades, many studies have shown interesting results regarding the bioactivity of compounds present in carob. The attention of the scientific public is increasingly attracted by dietary fibre, cyclitols, polyphenols and tannins present in carob. These compounds are thought to be responsible for the health benefits that carob provides, including anti-cancer, anti-diabetic, anti-diarrheal and anti-hyperlipidemic effects [12,13,14]. Carob attracts the attention of scientists because its extracts have shown very strong antimicrobial activity against many types of bacteria and moulds [3,8,15,16]. Carob extracts in vitro show a high antioxidant potential, while in vivo they significantly reduce cerebral and myocardial lipid peroxidation, as well as the level of hydrogen peroxide in the kidneys, liver and brain. Also, the anti-dyslipidemic, anti-obesity and hepatoprotective potential of carob pulp was confirmed in the treatment of high-fat-diet-fed rats [17]. Therefore, carob polyphenol extracts can be used as natural antioxidants in the food industry and can replace synthetic additives [18].
The addition of functional components can have a negative impact on the rheological properties of the dough and the sensory quality of the finished products, which is why great attention is paid to the optimization of the raw composition of enriched bakery products. The addition of bioactive compounds is known to affect dough development [19], because antioxidants can form complexes with proteins and polysaccharides. In this paper, the possibility of using carob extract in the production of bread, as a potential natural preservative and functional additive, was examined.
2. Materials and Methods
2.1. Ingredients
The carob pulp flour used in this study for obtaining extracts originated from Croatia and was purchased as a commercial product available in Serbia (Aroma začini, D.O.O. Futog, Serbia). Materials used for the preparation of bread were wheat flour—(K-plus, Belgrade, Serbia; 13.4% moisture, 11.8% protein), salt (Solana d.d., Tuzla, BiH) and bread yeast (Lesaffre, Budapest, Hungary).
2.2. Chemicals
Chemicals which were purchased from Sigma-Aldrich Chem (Steinheim, Germany) were the following: Folin–Ciocalteu reagent, gallic acid, (±)-catechin, 2,2-diphenyl-1-picrylhydrazyl (DPPH), TPZT (2,4,6-tris (2-pyridil)-s triazine), ABTS (2,2′-azino-bis-(-3-ethylbenzothiazoline-6-sulfonic acid) diammonium salt), iron (III)-chloride, iron (II)-sulfatheptahydrate and potassium persulfate. Trolox (6-hydroxy-2,5,7,8-tetramethylchroman-2-carboxylic acid) was purchased from Sigma-Aldrich (Milano, Italy), while maltodextrin was purchased from Brenntag (Mülheim, Germany). All other reagents were of analytical grade.
2.3. Carob Flour Extract Preparation
In our previous work [20], the optimization of microwave-assisted extraction parameters (extraction time, ethanol concentration and microwave irradiation power) was carried out and the carob flour extract sample that showed the highest antioxidant activity was selected for investigation in this research. Extraction was performed in a remodelled commercial microwave oven (NN-E20W, Panasonic, Osaka, Japan). Briefly, 10.0 g of carob flour was mixed with 100 mL of ethanol (concentration 40% w/w) in the round flask, which was then connected to the condenser and placed in the microwave oven. Extraction was carried out for 25 min, with irradiation power set to 800 W. After cooling, the obtained extract was centrifuged and collected in glass flasks. When a sufficient amount of liquid extract had been obtained, it was prepared for drying.
2.4. Spray Drying
Maltodextrin (DE ˂ 5) was dissolved in water and added to the prepared extract in a ratio of maltodextrin–dry extract residue = 1:1, then mixed and homogenized. The prepared feed was pumped into a pilot Anhydro spray dryer plant (APV Anhydro AS, Soborg, Denmark) using a peristaltic pump (FH100 Series, Thermo Scientific, Waltham, MA, USA) with a flow rate of 1.36 L/h. The inlet temperature was 135–145 °C. For the atomization of the liquid extract, a rotary disk with speed range 20,000 to 21,000 rpm was used. After drying, i.e., evaporation of the solvent, the dry extract was separated from the hot air in a cyclone and collected in a receiving vessel. The obtained powdered carob extract (CP) was collected in a glass container and stored, protected from air and moisture, at room temperature.
2.5. Bread Production
Bread dough of the control sample (C) consisted of the following raw materials: 900 g wheat flour, 2% table salt, 3% yeast and water in accordance with the water absorption obtained by the farinograph (55.6%). Powdered carob extract (CP) was added to the dough in amounts of 0.5, 1.5; 2.5 and 3.5% (on a flour weight basis) in order to produce samples E0.5%, E1.5%, E2.5% and E3.5%, respectively. Kneading lasted 4 min at 450 rpm in a MS-6 mixer, after which the dough was placed in a fermentation chamber (30 °C) for 60 min. The dough was then divided into 3 pieces of 300 g each, rounded and left covered on the work table for intermediate fermentation for 10 min. Then, the tested pieces were moulded and placed on baking pans for final proofing (around 60 min at 30 °C and 85% RH). Samples were baked at 250 °C in the Chopin laboratory oven. The end of baking was determined by controlling a mass loss of 10%. Bread samples were cooled for 2 h, and were then packed in polyethylene bags and stored at ambient conditions until further analysis.
2.6. Microbial Load of Bread Samples
Microbiological analyses were conducted 24 h after baking. Briefly, 10 g of bread crumb samples were added to 90 mL of sterile saline and homogenized in a Stomahcer 400 Circulator for 2 min. After that, serial dilutions of 10−2, 10−3 and 10−4 in the same diluent were prepared and 0.1 mL of each dilution was incubated on the appropriate microbiological media: for aerobic mesophilic bacteria on plate count agar (PCA) for 2 days at 30 °C [21], and for yeast and moulds on dichloran rose-bengal chloramphenicol agar (Biolife, Milan, Italy) for 5 days at 28 °C [22]. For the presence of spores of aerobic bacteria, a 2 mL sample of the initial dilution was heated at 80 °C for 12 min. Afterwards, dilutions of 10−2 and 10−3 were prepared, and 0.1 mL from each was transferred onto PCA agar plates. The plates were then incubated for 48 h, and the results were read. Colony growth represents the presence of spores of aerobic bacteria [23]. The presence of Bacillus cereus was determined by the inoculation of 0.1 mL initial dilution onto Bacillus cereus agar (BCA) medium. It was incubated for 1 to 2 days at 37 °C. Green-blue colonies with a clear culture zone indicate the presence of Bacillus cereus [24].
2.7. Challenge Test
From each bread sample, 3 slices were aseptically cut with a sterile knife and transferred into square Petri dishes. Spore suspensions were prepared with Aspergillus flavus and Penicillium verrucosum from the collection of the Laboratory for Food microbiology, Biotechnical Faculty, University of Ljubljana, Slovenia. Then, 10 μL of the spore suspension was applied to the centre of each bread slice. Samples were sealed in Petri dishes and stored for 10 days at 22 °C, while the mould growth was measured daily [25].
2.8. Extraction of Phenols from Bread Samples
In order to examine the biochemical characteristics of bread, pohyphenols were extracted from the obtained samples. Briefly, 3.0 g of bread crumb was mixed with 15 mL 70% ethanol (w/w) in a cuvette and placed into a rotary thermostat at 25 °C, 65 rpm for 15 min. Samples were centrifuged (3000 rpm, 10 min) and the supernatant was used for further analysis.
2.9. Total Phenol Content
The total phenols (TP) content in bread samples was determined by the Folin–Ciocalteu procedure [26]. The standard calibration curve was prepared using gallic acid. The absorbance of the samples was measured at 750 nm (6300 Spectrophotometer, Jenway, UK). Phenolic compound content was expressed as mg of gallic acid equivalents (GAE) per gram of bread.
2.10. Antioxidant Activity
The ability to neutralize DPPH (1,1-diphenyl-2-picrylhydrazyl) radicals was determined by a slightly modified method described by Espín et al. [27]. A methanol solution of DPPH reagent (65 µM) was freshly prepared, and the absorbance was adjusted to 0.70 (±0.02). The DPPH reagent was added to appropriate dilutions of the extracts (2.9 mL + 0.1 mL), and the reaction mixture was incubated for 60 min. Absorbance was measured at 517 nm using a spectrophotometer (6300 Spectrophotometer, Jenway, UK). The calibration curve was obtained using a freshly prepared aqueous solution of Trolox. The results were expressed as µM of Trolox equivalents (TE) per gram of bread.
The ability to neutralize ABTS radicals was determined by a spectrophotometric method [28]. For the preparation of the ABTS reagent, a mixture of 7 mM aqueous solution of 2,2’-azino-bis (3-ethylbenzothiazoline-6-sulfonic acid) diammonium salt (ABTS) and 2.45 mM potassium persulfate in a 1:1 (v/v) ratio was prepared, and the resulting solution was incubated for 16 h in the dark at room temperature. The obtained ABTS reagent was diluted with acetate buffer (pH 3.3) to adjust the absorbance to 0.70 ± 0.02 at 734 nm. Appropriate dilutions of the extracts (0.1 mL) were mixed with 2.9 mL of the ABTS reagent, and the reaction mixture was incubated at room temperature in the dark for 300 min. Absorbance was measured at 734 nm. A calibration curve was generated using a water solution of Trolox. The results were expressed as μM of Trolox equivalents (TE) per gram of bread.
The ability to reduce Fe3+ ions (Ferric-ion-reducing antioxidant power) is determined by the FRAP (Ferric-Reducing Antioxidant Power) assay [29]. The FRAP reagent was prepared by mixing 10 mmol/L 2,4,6-tripyridyl-s-triazine (TPTZ) in 40 mmol/L HCl, 0.02 mol/L FeCl3 and acetate buffer (pH 3.6) in a 1:1:10 (v/v/v) ratio. Bread extracts (0.1 mL) were mixed with 2.9 mL of FRAP reagent and incubated at 37 °C for 10 min in the dark. The absorbance of the samples was then measured at 593 nm. The series of freshly prepared Fe2+ (Fe2SO4) aqueous solutions was used for obtaining the calibration curve. Results were expressed as µM of Fe2+ equivalents per gram of bread.
2.11. Bread Colour
Colour parameters of bread samples were measured using the Minolta Chroma Meter CR-400 colorimeter with an 8 mm aperture on the measurement head (Konica Minolta Inc., Osaka, Japan). The colour parameters of the crumb and crust of bread samples were measured using the standard CR-A33b attachment. Measurements were conducted under D-65 illumination with a standard viewing angle of 2° in ten repetitions for crumb colour and ten repetitions for crust colour. The colour of the bread was expressed in the CIE L*a*b* colour space [30] with L*—representing the lightness of colour, a*—representing the redness (+) or greenness (−), and b*—representing the yellowness (+) or blueness (−).
2.12. Textural Properties
Texture measurements of the bread crumb were conducted 24 h after baking using the TA.HDPlus Texture Analyser (Stable Micro Systems, Godalming, UK) employing the Texture Profile Analysis (TPA) test (double compression method), which simulates the chewing process in the mouth. Bread slices with a thickness of 18 mm were cut. The sample was loaded with a weight up to 45% of the sample thickness. The first testing speed was 10 mm/s, and the second was 5 mm/s [31]. Each bread sample was analysed in five replicates for hardness, cohesiveness, chewiness and resilience.
2.13. Sensory Analysis
The evaluation was performed 24 h after baking by 25 untrained panellists (18 male and 17 female), bread consumers, in the age range of 20–50 years. Bread samples were coded with 3-digit numbers. An overall acceptability test was conducted [32]. A five-point hedonic scale (1: dislike extremely, 3: neither like nor dislike and 5: like extremely) was used for the evaluation of the bread’s quality attributes, such as crust colour, crumb colour, crust appearance, crumb firmness, aroma, flavour and overall acceptability. Fresh water was provided to the panellists to rinse their mouths between testing the samples.
2.14. Statistical Analysis
Statistical analysis was performed using the STATISTICA 14.0.0.15 software (TIBCO Statistica™, Palo Alto, CA, USA), applying Duncan’s test in the analysis of variance (one-way ANOVA) to estimate the significance of the differences between the mean values at p < 0.05.
3. Results and Discussion
3.1. Microbial Load of Bread Samples
The number of total aerobic bacteria, sporogenous bacteria, yeasts and moulds and the presence of Bacillus cereus in bread samples are shown in Table 1.

Table 1.
Results of microbial load of bread samples.
The highest number of total aerobic bacteria was observed in the control sample (4.84 ± 0.53 log CFU/g). As expected, with an increase in the carob extract content in the bread, the number of total aerobic bacteria decreased, confirming the inhibitory activity of the carob extract on bacteria. Similar results were obtained by examining the amount of sporogenous bacteria, which were not detected in any bread sample with the addition of CP. Moreover, in the control sample and the sample with the lowest amount of CP (E0.5%), the presence of B. cereus was observed, while in samples with higher CP amounts B. cereus growth was not observed. In the control sample and sample E0.5%, there was a change in the colour of the nutrient medium from yellow to a characteristic dark blue (Figure 1a,b). In Figure 1b, the sample with the maximum amount of extract (E3.5%) is shown, demonstrating the absence of B. cereus. Spores of B. cereus can be found in raw materials of bakery products [33], and it is known that they are able to survive the baking process [34]. Moreover, Jaaskelainen et al. [35] showed that in bakery products B. cereus can produce cereulide, the emetic toxin of the mentioned sporogenous bacteria, and therefore, the absence of B. cereus in bread with CP is a clear indicator of the improved microbiologival safety, compared to bread without CP.

Figure 1.
The presence of B. cereus in the control sample (a) and the absence of B. cereus in the sample with 3.5% powdered carob extract (b).
The antimicrobial effect of carob is associated with the presence of bioactive compounds, mainly phenolic acids, flavonoids and their glycosides, which affect the growth and development of microorganisms. In our previous study, the presence of gallic, caffeic, p-coumaric and chlorogenic acid, as well as quercetin, quercitrin and rutin, were determined in significant amounts [20]. The antimicrobial activity of some of the polyphenolic compounds mentioned were tested against various microorganisms [36]. It is assumed that the antimicrobial activity of CP is mainly the effect of gallic acid, since it is the dominant polyphenolic compound in carob. Pinho et al. [36] showed that gallic acid exhibited a greater antibacterial effect at lower concentrations against tested Gram-positive and Gram-negative bacteria, compared to caffeic acid, rutin and quercetin. The antibacterial effectiveness of flavonoids stems from their capability to form complexes with extracellular and soluble proteins, as well as their ability to disrupt bacterial cell walls by interacting with vital enzymes that uphold the integrity of this structure [37]. The obtained results of the microbial load of bread with CP are comparable to results of other studies that examined the effect of the addition of functional materials with similar phenol/flavonoid profiles. Sagar and Pareek [38] reported that the introduction of a higher share of onion skin powder, which is rich in quercetin, in bread formulations resulted in an extended shelf-life of the produced bread by lowering the bacterial and fungal count compared to the control sample.
Yeast and mould were not observed in any of the samples, which is in accordance with the Regulation on the Microbiological Safety of Food in Circulation, which states that bakery products must not contain more than 1000 yeasts and moulds per 1 g [39].
3.2. Challenge Test
To obtain a more comprehensive understanding of the antimicrobial potential of carob extract as a natural preservative, a microbiological inoculation test was conducted. This test monitored changes in the product during its shelf life after the intentional/targeted inoculation of the product with the desired microorganism. The application of this microbiological test is significant in the development of new products with the addition of raw materials that have potential antimicrobial effects [40].
Mould spoilage is the most common form of microbiological spoilage in food products, especially bread, and leads to large economic losses as well as potential health hazards to consumers due to the production of mycotoxins by moulds. For the bread inoculation test, moulds that are the most common contaminants of bread were selected—Aspergillus flavus and Penicillium verrucosum [41]. Figure 2 shows the development of Penicillium verrucosum mould on bread slices over time and Figure 3 shows the development of Aspergillus flavus. Figure 2 shows that moulds appeared on all samples on the third day, with an increase in colony size observed in the following days. The highest mould growth was observed in the control sample, followed by the sample with the lowest amount of CP (0.5%). From day four until the end of the monitoring period, on samples with a higher concentration of extract mould, growth was significantly lower compared to control and the E0.5% sample, indicating the inhibitory effect of CP on the growth of Penicillium verrucosum.

Figure 2.
Development of Penicillium verrucosum over time.

Figure 3.
Development of Aspergillus flavus over time.
A. flavus was visually detected on day 2, and its growth on bread samples with CP was comparable to the control until day 3. From day 4, the mycelia diameter on samples with CP, regardless of the applied amount, was significantly different from the control sample. At the end of monitoring period, mould growth was highest in sample E1.5% and lowest in sample E2.5% (Figure 3). The obtained results indicated a lower inhibitory effect of CP addition in bread on A. flavus development compared to P. verrucosum.
Al-Khail et al. [42] and Sittisart et al. [43] concluded that plant extracts have strong antifungal activity and that the inhibitory effect of plant extracts on the examined pathogenic fungi is proportional to the applied concentrations. Unexpectedly, the maximum concentration of CP did not result in the highest inhibition of A. flavus in our study; rather, it even led to the stimulation of fungal growth. It is assumed that this is due to the microorganisms’ response to environmental stress, which leads to their more intensive reproduction [43]. These results suggest that in the case of A. flavus, additional research should be conducted, including the application of various concentrations of the CP.
The inhibitory effect on mould growth in bread with CP could be attributed to the antifungal effect of ellagitannins [44], which are also present in carob pods and were reported in the literature [45]. The antifungal activity in bread fortified with rambutan peel extract contributed to the extension of bread shelf life, due to the inhibitory compound (corilagin), which protected bread from spoilage [44].
3.3. Antioxidant Potential of Bread with the Addition of Carob Extract
The antioxidant potential of bread with the addition of CP was defined based on the results of total phenol content (TP), as well as the in vitro antioxidant activity determined by DPPH, FRAP and ABTS tests (Table 2).

Table 2.
Total phenolic content and antioxidant activity of bread with the addition of powdered carob extract.
It can be noted that the addition of CP caused the increment of TP content in the obtained bread samples. The highest TP content (0.27 mg GAE/g) was observed in sample E3.5%, and was two times higher in comparison to the control. The ability to neutralize DPPH radicals was significantly increased (p < 0.05), even by the addition of the lowest amount of CP (0.5%), which was also the case when observing the reducing power towards Fe3+ (FRAP). The antioxidant activity of bread determined by the ABTS assay was significantly higher (p < 0.05) compared to the control sample when the amount of 1.5% of CP was applied. The highest values for in vitro antioxidant activity were achieved by the addition of 3.5% of CP: DPPH of 1.24 µM TE/g (31 times higher), FRAP of 1.19 µM Fe2+/g (1.7 times higher) and ABTS of 1.96 µM TE/g (2.3 times higher compared to the control).
Even though the application of carob flour extract in breadmaking has not yet been examined in the literature, the obtained results are in accordance with research publications that have investigated the addition of other types of plant extracts [46,47]. On the basis of the obtained results, it was confirmed that with the addition of CP the bread had significantly higher bioactive compound content, i.e., higher antioxidant activity compared to white wheat bread, which contributes to its functionality.
3.4. Colour of the Bread Crust and Crumb
The results of lightness L* (luminance) and parameters a* (red to green) and b* (blue to yellow) are shown in Table 3. Lightness is the achromatic component ranging from 0 to 100, where 0 represents black and 100 represents white, while a and b are chromatic components. The parameter a* indicates the proportion of the red tone when positive and the green tone when its value is negative. Positive values of the parameter b* indicate the proportion of yellow colour, while negative values indicate blue [48].

Table 3.
Colour parameters of bread samples.
The L* value of the crust and crumb of bread was highest for the control sample and decreased with increasing content of CP in the bread. The difference in L* values was not statistically significant (p > 0.05) for the control sample and sample E0.5%. Statistically significant changes in the brightness of the crust and crumb began with a CP content of 1.5%. The darker colour of samples with a higher amount of CP was due to the characteristic brown colour of carob, which originates from the presence of a large amount of tannins. Also, maltodextrin usually contributes to a reduction in L* while increasing a* and b* values [49].
The control sample had the lowest value of the parameter a* for the crust colour (7.57 ± 0.20), and the proportion of the red tone steadily increased up to a value of 12.82 ± 0.80 (sample with maximum addition of CP). The negative value of the parameter a* in the control sample indicated the presence of a slight green tone in the crumb colour. With the CP addition, the green tone diminished and the red tone appeared. As the content of the CP increased, the value of this parameter increased with statistical significance (p < 0.05). The parameter b* had a maximum value for the control sample, for crust colour (32.19 ± 2.41) and crumb colour (16.05 ± 0.57). With a higher content of CP, a decrease in the b* value was observed, indicating a reduction in the intensity of the yellow tone in both the crust and crumb of the bread.
3.5. Textural Parameters of the Bread Crumb
The texture of the bread crumb can vary widely depending on factors such as ingredients, preparation methods and baking techniques, but needs to be soft, cohesive and resilient [16]. The texture of the bread crumb was analysed to obtain a more comprehensive understanding of the characteristics of bread with the addition of carob. The influence of adding carob extract on the textural properties of bread is depicted in Table 4.

Table 4.
Textural properties of bread samples.
The addition of 0.5% CP did not significantly affect crumb hardness (p > 0.05) compared to the control bread sample. The hardness of the bread crumb with the addition of a higher amount of CP was higher than the control sample, but there was no statistically significant (p > 0.05) difference in firmness when increasing CP quantity from 1.5 to 3.5%. The addition of maltodextrin can increase the firmness of the crumb [50], while the fibres and polyphenols present in the carob encapsulate may compete for water with native wheat starch granules in the dough and also result in higher firmness [51]. Bread firmness directly affects chewiness, as confirmed by the values in Table 4. Chewiness could be explained as the energy needed when chewing solid or semi-solid food, and the higher the value, the harder it is to chew. The addition of CP statistically significantly increased bread crumb chewiness, which means that more energy is needed when chewing. With an increased carob extract level, a decrease in cohesiveness in the bread was observed, which means that the internal resistance of the bread structure decreased, but that this reduction was not statistically significant, as can be seen in Table 3. The springiness of bread samples statistically significantly decreased with the addition of 1.5, 2.5 and 3.5% of CP, which might be due to the weaker and less elastic gluten structure. These results are consistent with the results of Šoronja-Simović et al. [16], who showed that with the addition of carob flour, there was a reduction in cohesiveness and resilience and an increase in hardness and chewiness in bread samples.
3.6. Sensory Analysis
Although we have proven that the addition of CP has numerous benefits in bread, if this addition negatively affects the sensory characteristics, it will not be accepted by consumers. Therefore, sensory analysis is a very important part of new product development. Figure 4 shows the structure of the bread samples, while the mean values of the attribute ratings for each bread sample are shown in Figure 5. As can be seen, the shape of all bread samples was regular, the crust colour was uniform, and samples with a higher amount of CP were slightly darker, but this did not prompt the panellists to give negative marks for the crust colour. The crust of all samples was thin and even, without cracks or holes. The colour and porosity of the crumb were relatively consistent, with some samples showing the presence of water rings, which may be a result of manual shaping. The crust colour was rated high for all samples, and the raters commented that the colour of the samples with the addition of CP reminded them of the colour of “healthy” types of bread that can be found on the market. The addition of CP positively influenced the aroma and taste of the bread. Taste and aroma were judged to be pleasant by the panel, with a noticeable characteristic carob scent and a slightly sweet taste.

Figure 4.
Appearance of the control sample of bread and samples with the addition of carob extract.

Figure 5.
Sensory analysis of bread samples.
The addition of the extrudate had a slightly more negative effect only on the structure of the bread crumb, due to an increase in hardness and a decrease in elasticity with an increase in the amount of CP, which is in accordance with the instrumental measurements on the texturometer. This entails a slight reduction in the volume of the loaf. However, this impact was not so significant as to cause unacceptability by the assessors, as can be seen from the results for general acceptability. Czubaszek et al. [52] showed that the addition of different extracts had no great effect on the volume of bread if maltodextrin was used as a carrier because of a positive effect of the addition of maltodextrin on the volume of bread [53], although polyphenolic compounds can inhibit the activity of yeast and reduce bread volume [54], which may be the reason for the slight decrease in volume in our study. The results definitively indicate that the addition of up to 3.5% CP has no negative impact on the sensory quality of the bread. It is also evident that the selected range of extract amounts in the experimental plan was not wide enough to closely identify differences in bread quality resulting from variations in the amount of added CP. It is assumed that from a sensory standpoint, CP could be added to bread in larger quantities, although the upper limit of its application should be defined.
4. Conclusions
Carob extract can be successfully included in the production of functional bread. The microbiological quality of fresh bread is significantly better in samples with the addition of carob extract, which is confirmed by the lower values of the total number of aerobic bacteria, the number of sporogenic bacteria and the absence of the Bacillus cereus. The results of the challenge test confirmed the inhibitory effect of carob extract on Penicillium verrucosum. The TP content in bread with 3.5% CP was two times higher than in the control sample. Also, the in vitro antioxidant activity in the bread sample with 3.5% CP was increased 31 times (DPPH), 1.7 times (FRAP) and 2.3 times (ABTS) compared to control. The addition of carob extract caused a change in the colour of the crust and crumb of the bread. As a function of the addition of the extract, the brightness of the samples decreased, while the share of the red tone increased, and the intensity of the yellow tone decreased. The aforementioned changes are a consequence of the characteristic colour of carob, which comes from tannins and other polyphenolic compounds present. The addition of carob extract reduced the cohesiveness and resilience and increased the hardness and chewiness of bread samples. The addition of up to 3.5% carob extract had no negative effect on the sensory quality of the bread. From a sensorial aspect, a larger amount of extract than the maximum tested could be used in the preparation of bread, and the upper limit of carob extract application should be defined.
Author Contributions
Conceptualization, J.Z. and D.Š.-S.; methodology, S.S.M. and M.S.; software, J.P.; validation, D.Š.-S. and S.S.M.; investigation, J.Z., M.S., B.P., Z.Š., Đ.A. and D.Š.; resources, J.P. and A.J.; writing—original draft preparation, J.P., J.Z. and A.J.; writing—review and editing, J.P., A.J., B.P., Đ.A., Z.Š. and D.Š.; visualization, Đ.A. and Z.Š.; supervision, B.P.; funding acquisition, D.Š. All authors have read and agreed to the published version of the manuscript.
Funding
This research was supported by the Ministry of Science, Technological Development and Innovations of the Republic of Serbia, No. 451-03-66/2024-03/200134 and No. 451-03-65/2024-03/200134, and the Provincial Secretariat for Higher Education and Scientific Research of Vojvodina (Project No. 142-451-2574/2021-01).
Institutional Review Board Statement
Not applicable.
Informed Consent Statement
Not applicable.
Data Availability Statement
Data is contained within the article.
Conflicts of Interest
The authors declare no conflicts of interest.
References
- Tomás-Barberán, F.A.; Ferreres, F.; Gil, M.I. Antioxidant phenolic metabolites from fruit and vegetables and changes during postharvest storage and processing. Stud. Nat. Prod. Chem. 2000, 23, 739–795. [Google Scholar] [CrossRef]
- Jain, T.; Jain, V.; Pandey, R.; Vyas, A.; Shukla, S.S. Microwave assisted extraction for phytoconstituents—An overview. Asian J. Res. Chem. 2009, 2, 19–25. [Google Scholar]
- Ibrahim, U.K.; Salleh, R.M.; Maqsood-ul-Haque, S.N.S. Bread towards Functional Food: An Overview. Int. J. Food Eng. 2015, 1, 39–43. [Google Scholar] [CrossRef][Green Version]
- Ioannou, I.; Hafsa, I.; Hamdi, S.; Charbonnel, C.; Ghoul, M. Review of the effects of food processing and formulation on flavonol and anthocyanin behaviour. J. Food Eng. 2012, 111, 208–217. [Google Scholar] [CrossRef]
- Lachowicz, S.; Michalska-Ciechanowska, A.; Oszmiański, J. The impact of maltodextrin and inulin on the protection of natural antioxidants in powders made of Saskatoon berry fruit, juice, and pomace as functional food ingredients. Molecules 2020, 25, 1805. [Google Scholar] [CrossRef]
- Kim, S.J.; Cho, A.R.; Han, J. Antioxidant and antimicrobial activities of leafy green vegetable extracts and their applications to meat product preservation. Food Cont. 2013, 29, 112–120. [Google Scholar] [CrossRef]
- Skandamis, P.N.; Nychas, G.J. Effect of oregano essential oil on microbiological and physico-chemical attributes of minced meat stored in air and modified atmospheres. J. Appl. Microbiol. 2001, 91, 1011–1022. [Google Scholar] [CrossRef] [PubMed]
- Hsouna, A.B.; Trigui, M.; Mansour, R.B.; Jarraya, R.M.; Damak, M.; Jaoua, S. Chemical composition, cytotoxicity effect and antimicrobial activity of Ceratonia siliqua essential oil with preservative effects against Listeria inoculated in minced beef meat. Int. J. Food Microbiol. 2011, 148, 66–72. [Google Scholar] [CrossRef] [PubMed]
- Newman, D.J.; Cragg, G.M. Natural products as sources of new drugs over the 30 years from 1981 to 2010. J. Nat. Prod. 2012, 75, 311–335. [Google Scholar] [CrossRef]
- Papadoupoulo, C.; Soulti, K.; Roussis, I.G. Potential antimicrobial activity of red and white wine phenolic extracts against strains of Staphyloccocus aureus, Escherichia coli and Candida albicans. Food. Technol. Biotechnol. 2005, 43, 41–46. [Google Scholar]
- Negi, P.S. Plant extracts for the control of bacterial growth: Efficacy, stability and safety issues for food application. Int. J. Food Microbiol. 2012, 156, 7–17. [Google Scholar] [CrossRef] [PubMed]
- Gruendel, S.; Otto, B.; Garcia, A.L.; Wagner, K.; Mueller, C.; Weickert, M.O.; Koebnick, C. Carob pulp preparation rich in insoluble dietary fibre and polyphenols increases plasma glucose and serum insulin responses in combination with a glucose load in humans. Br. J. Nutr. 2007, 98, 101–105. [Google Scholar] [CrossRef] [PubMed]
- Zunft, H.J.; Luder, W.; Harde, A.; Haber, B.; Graubaum, H.J.; Koebnick, C.; Grunwald, J. Carob pulp preparation rich in insoluble fibre lowers total and LDL cholesterol in hypercholesterolemic patients. Eur. J. Nutr. 2003, 42, 235–242. [Google Scholar] [CrossRef] [PubMed]
- Klenow, S.; Glei, M.; Haber, B.; Owen, R.; Pool-Zobel, B.L. Carob fibre compounds modulate parameters of cell growth differently in human ht29 colon adenocarcinoma cells than in LT97 colon adenoma cells. Food Chem. Toxicol. 2008, 46, 1389–1397. [Google Scholar] [CrossRef] [PubMed]
- Kivçak, B.; Mert, T.; Öztürk, H.T. Antimicrobial and cytotoxic activities of Ceratonia siliqua L. extracts. Turk. J. Biol. 2002, 26, 197–200. [Google Scholar]
- Šoronja-Simović, D.; Zahorec, J.; Šereš, Z.; Griz, A.; Sterniša, M.; Smole Možina, S. The food industry by-products in bread making: Single and combined effect of carob pod flour, sugar beet fibers and molasses on dough rheology, quality and food safety. J. Food Sci. Technol. 2022, 59, 1429–1439. [Google Scholar] [CrossRef] [PubMed]
- Rašković, A.; Martić, N.; Tomas, A.; Andrejić-Višnjić, B.; Bosanac, M.; Atanasković, M.; Nemet, M.; Popović, R.; Krstić, M.; Vukmirović, S.; et al. Carob Extract (Ceratonia siliqua L.): Effects on Dyslipidemia and Obesity in a High-Fat Diet-Fed Rat Model. Pharmaceutics 2023, 15, 2611. [Google Scholar] [CrossRef] [PubMed]
- Loullis, A.; Pinakoulaki, E. Carob as cocoa substitute: A review on composition, health benefits and food applications. Eur. Food Res. Technol. 2018, 244, 959–977. [Google Scholar] [CrossRef]
- Sivam, A.; Sun-Waterhouse, D.; Waterhouse, G.I.N.; Quek, S.Y.; Perera, C.O. Physicochemical properties of bread dough and finished bread with added pectin fiber and phenolic antioxidants. J. Food Sci. 2011, 76, H97–H107. [Google Scholar] [CrossRef]
- Martić, N.; Zahorec, J.; Stilinović, N.; Andrejić-Višnjić, B.; Pavlić, B.; Kladar, N.; Rašković, A. Hepatoprotective effect of carob pulp flour (Ceratonia siliqua L.) extract obtained by optimized microwave-assisted extraction. Pharmaceutics 2022, 14, 657. [Google Scholar] [CrossRef]
- ISO 4833-1; Microbiology of the Food Chain—Horizontala Method for the Enumeration of Microorganisms—Part 1: Colony Count at 30 Degrees C by the Pour Plate Technique. International Organization for Standardization (ISO): Geneva, Switzerland, 2013.
- ISO 7954:1987; Microbiology—General Guidance for Enumeration of Yeasts and Moulds—Colony Count Technique at 25 Degrees C. International Organization for Standardization (ISO): Geneva, Switzerland, 1987.
- Harrigan, W.F. Laboratory Methods in Food Microbiology, 3rd ed.; Academic Press: San Diego, CA, USA, 1998. [Google Scholar]
- ISO 7932:2004; Microbiology of Food and Animal Feeding Stuffs–Horizontal Method for the Enumeration of Presumptive Bacillus cereus–Colony-Count Technique at 30 Degrees C. International Organization for Standardization (ISO): Geneva, Switzerland, 2004.
- Samapundo, S.; de Baenst, I.; Eeckhout, M.; Devlieghere, F. Inhibitory activity of fermenters towards Zygosaccharomyces bailii and their potential to replace potassium sorbate in dressings. Lebensm.-Wiss. Technol. 2017, 79, 309–315. [Google Scholar] [CrossRef]
- Singleton, V.L.; Rossi, J.A. Colorimetry of total phenolics with phosphomolybdic-phosphotungstic acid reagents. Am. Soc. Enol. Vitic. 1965, 16, 144–158. [Google Scholar] [CrossRef]
- Espín, J.C.; Soler-Rivas, C.; Wichers, H.J. Characterization of the total free radical scavenger capacity of vegetable oils and oil fractions using 2,2-diphenyl-1-picrylhydrazyl radical. J. Agric. Food Chem. 2000, 48, 648–656. [Google Scholar] [CrossRef] [PubMed]
- Re, R.; Pellegrini, N.; Proteggenete, A.; Pannala, A.; Yang, M.; Rice-Evans, C. Antioxidant activity applying an improved ABTS radical cation decolorization assay. Free Radic. Biol. Med. 1999, 26, 1231–1237. [Google Scholar] [CrossRef] [PubMed]
- Oyaizu, M. Studies on products of browning reaction. Antioxidative activities of products of browning reaction prepared from glucosamine. Jpn. J. Nutr. Diet. 1986, 44, 307–315. [Google Scholar] [CrossRef]
- CIE. International Commission on Illumination, Colorimetry: Official Recommendation of the International Commission on Illumination; Publication CIE No. (E-1.31); Bureau Central de la CIE: Paris:, France, 1976. [Google Scholar]
- American Association of Cereal Chemists. Approved Methods of the AACC; Method 74-09; The Association: St. Paul, MN, USA, 2000. [Google Scholar]
- Stone, H.; Sidel, J.L. Sensory Evaluation Practices, 3rd ed.; Elservier Academic Press: California, CA, USA, 2004; p. 377. [Google Scholar]
- Rosenkvist, H.; Hansen, Å. Contamination profiles and characterization of Bacillus species in wheat bread and raw materials for bread production. Int. J. Food Microbiol. 1994, 26, 353–363. [Google Scholar] [CrossRef]
- Kaur, P. Survival and growth of Bacillus cereus in bread. J. Appl. Bacteriol. 1986, 60, 513–516. [Google Scholar] [CrossRef] [PubMed]
- Jääskeläinen, E.L.; Häggblom, M.M.; Anderson, M.A.; Vanne, L.; Salkinoja-Salonen, M.S. Potential of Bacillus cereus for producing an emetic toxin, cereulide, in bakery products: Quantitative analysis by chemical and biological methods. J. Food Prot. 2003, 66, 1047–1054. [Google Scholar] [CrossRef]
- Pinho, E.; Ferreira, I.; Barros, L.; Carvalho, A.M.; Soares, G.; Henriques, M. Antibacterial potential of northeastern Portugal wild plant extracts and respective phenolic compounds. BioMed Res. Int. 2014, 2014, 814590. [Google Scholar] [CrossRef]
- Cushnie, T.P.T.; Lamb, A.J. Antimicrobial activity of flavonoids. Int. J. Antimicrob. Agents 2005, 26, 343–356. [Google Scholar] [CrossRef]
- Sagar, N.A.; Pareek, S. Fortification of multigrain flour with onion skin powder as a natural preservative: Effect on quality and shelf life of the bread. Food Biosci. 2021, 41, 100992. [Google Scholar] [CrossRef]
- Pravilnik o Mikrobiološkoj Ispravnosti Namirnica u Prometu (2002). Official Gazette of the Federal Republic of Yugoslavia, No. 26/93, 53/95, and 46/2002. Available online: http://demo.paragraf.rs/demo/combined/Old/t/t2002_09/t09_0001.htm (accessed on 21 April 2024).
- Notermans, S.; In’t Veld, P. Microbiological challenge testing for ensuring safety of food products. Int. J. Food Microbiol. 1994, 24, 33–39. [Google Scholar] [CrossRef] [PubMed]
- Saranraj, P.; Geetha, M. Microbial spoilage of bakery products and its control by preservatives. Int. J. Pharm. Biol. Arch. 2012, 3, 38–48. [Google Scholar]
- Al-Khail, A.A. Antifungal activity of some extracts against some plant pathogenic fungi. Pak. J. Biol. Sci. 2005, 8, 413–417. [Google Scholar] [CrossRef]
- Sittisart, P.; Yossan, S.; Prasertsan, P. Antifungal property of chili, shallot and garlic extracts against pathogenic fungi, Phomopsis spp., isolated from infected leaves of para rubber (Hevea brasiliensis Muell. Arg.). J. Agric. Nat. Resour. 2017, 51, 485–491. [Google Scholar] [CrossRef]
- Torgbo, S.; Sukatta, U.; Kamonpatana, P.; Sukyai, P. Ohmic heating extraction and characterization of rambutan (Nephelium lappaceum L.) peel extract with enhanced antioxidant and antifungal activity as a bioactive and functional ingredient in white bread preparation. Food Chem. 2022, 382, 132332. [Google Scholar] [CrossRef] [PubMed]
- Avallone, R.; Plessi, M.; Baraldi, M.; Monzani, A. Determination of chemical composition of carob (Ceratonia siliqua): Protein, fat, carbohydrate and tannins. J. Food. Comp. Anal. 1997, 10, 166–172. [Google Scholar] [CrossRef]
- Czaja, A.; Czubaszek, A.; Wyspianska, D.; Sokoł-Łeztowska, A.; Kucharska, A.Z. Quality of wheat bread enriched with onion extract and polyphenols content and antioxidant activity changes during bread storage. Int. J. Food Sci. Technol. 2020, 55, 1725–1734. [Google Scholar] [CrossRef]
- Peng, X.; Ma, J.; Cheng, K.-W.; Jiang, Y.; Chen, F.; Wang, M. The effects of grape seed extract fortification on the antioxidant activity and quality attributes of bread. Food Chem. 2010, 119, 49–53. [Google Scholar] [CrossRef]
- Strgar Kurečić, M. Uvođenje CGRT Testne Karte Boja za Karakterizaciju Digitalnog Fotografskog Sustava. Ph.D. Thesis, Grafički fakultet, Zagreb, Croatia, 2007. [Google Scholar]
- Czubaszek, A.; Czaja, A.; Sokół-Łętowska, A.; Kolniak-Ostek, J.; Kucharska, A.Z. Changes in Antioxidant Properties and Amounts of Bioactive Compounds during Simulated In Vitro Digestion of Wheat Bread Enriched with Plant Extracts. Molecules 2021, 26, 6292. [Google Scholar] [CrossRef]
- Miyazaki, M.; Maeda, T.; Morita, N. Effect of various dextrin substitutions for wheat flour on dough properties and bread qualities. Food Res. Int. 2004, 7, 59–65. [Google Scholar] [CrossRef]
- Pasrija, D.; Ezhilarasi, P.N.; Indrani, D.; Anandharamakrishnan, C. Microencapsulation of green tea polyphenols and its effect on incorporated bread quality. Lebensm.-Wiss. Technol. 2015, 64, 289–296. [Google Scholar] [CrossRef]
- Czubaszek, A.; Czaja, A.; Sokół-Łętowska, A.; Kolniak-Ostek, J.; Kucharska, A.Z. Quality of bread enriched with microencapsulated anthocyanin extracts during in vitro simulated digestion. J. Cereal Sci. 2023, 113, 103724. [Google Scholar] [CrossRef]
- Karolini-Skaradzińska, Z.; Czubaszek, A.; Stanisławska, M.; Szewców, P. Zmiany właściwości wypiekowych mąki pszennej pod wpływem dodatku maltodekstryn. Żywność Nauka Technol. Jakość 2012, 4, 108–121. [Google Scholar]
- Kimani, B.G.; Kerekes, E.B.; Szebenyi, C.; Krisch, J.; Vágvölgyi, C.; Papp, T.; Takó, M. In vitro activity of selected phenolic compounds against planktonic and biofilm cells of food-contaminating yeasts. Foods 2021, 10, 1652. [Google Scholar] [CrossRef]
Disclaimer/Publisher’s Note: The statements, opinions and data contained in all publications are solely those of the individual author(s) and contributor(s) and not of MDPI and/or the editor(s). MDPI and/or the editor(s) disclaim responsibility for any injury to people or property resulting from any ideas, methods, instructions or products referred to in the content. |
© 2024 by the authors. Licensee MDPI, Basel, Switzerland. This article is an open access article distributed under the terms and conditions of the Creative Commons Attribution (CC BY) license (https://creativecommons.org/licenses/by/4.0/).